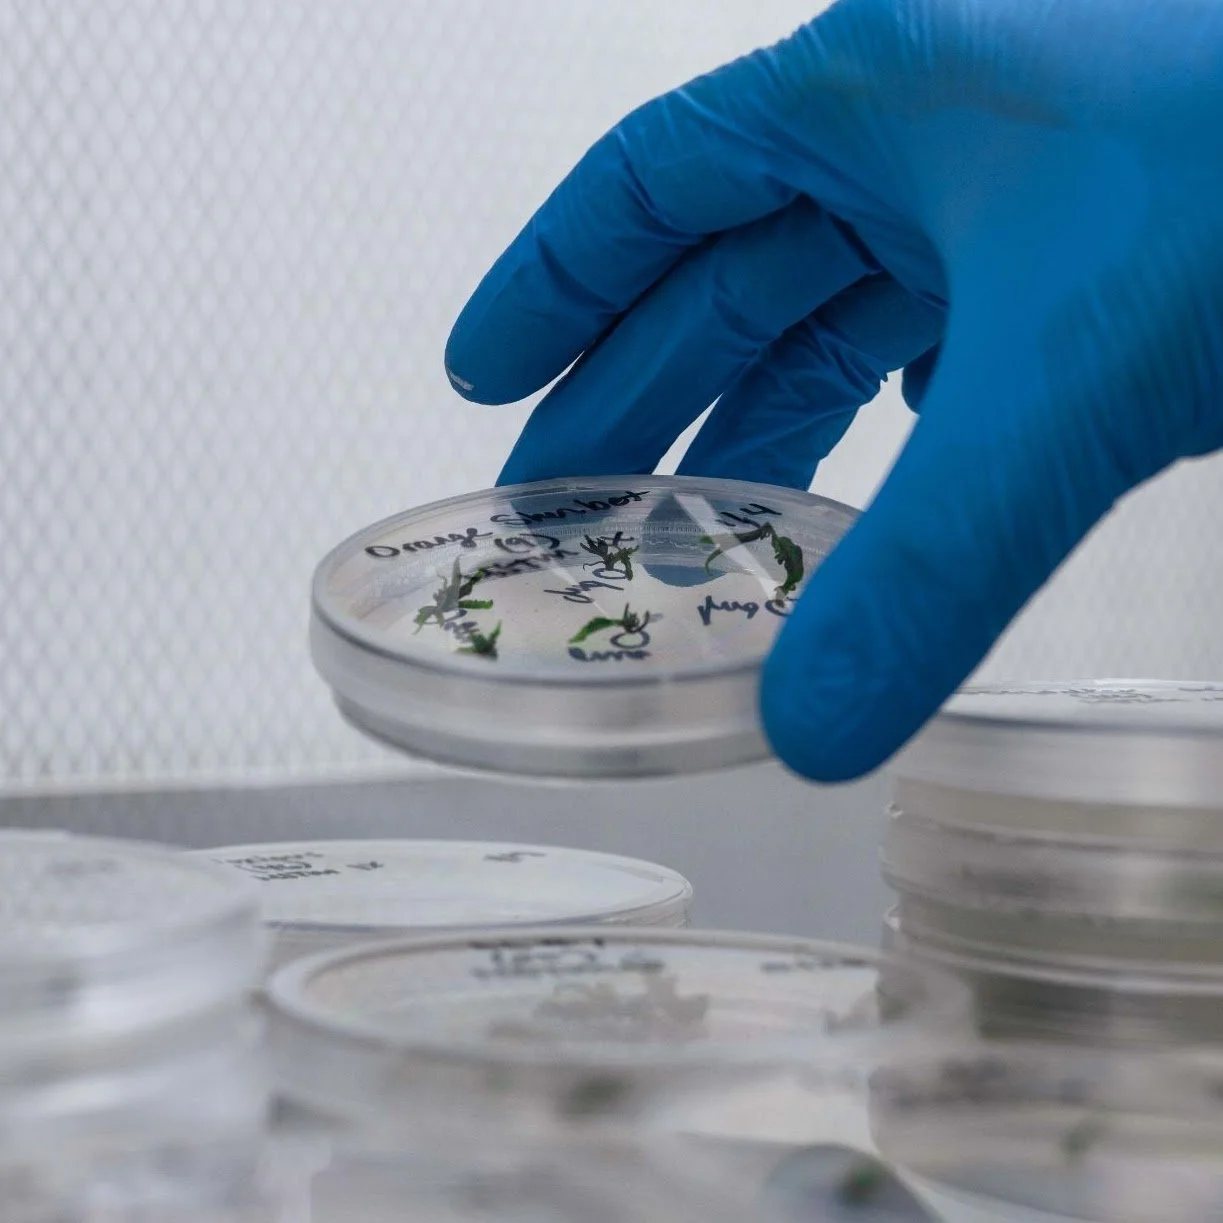
A gloved hand placing a petri dish with plant samples. Several petri dishes are stacked on a table.

Phinest Tissue Culture
Start Clean, Stay Clean.

Proven techniques,
Predicted outcomes
We are a California based tissue culture lab that stores hundreds of unique cultivars in our germplasm bank. All genetics we initiate have been through our proven meristem tip culture initiation procedure and are rigorously tested for pathogens.
Our innovative techniques, along with consistent execution, are the foundation of our clean plant program.
We know clean plants.
Our Mission
Phinest Tissue Culture's goal is to extend elite genetics, provide tissue culture technology and nursery operations to cannabis cultivators worldwide. We are elevating the cannabis industry to the standards of modern agriculture by making clean stock widely available.



Elite Plants, Every Time.
Our unique meristem tip isolation procedure yields much more consistent results in remediating pathogens when compared with standard nodal culture.
We provide you with elite genetics that are true to type and exhibit enhanced vigor. Our processes have proven effective in completely remediating HLVd. Remediated plants continue to test negative for pathogens several years after completing our clean plant program.

Not in California? No problem.
We’re quickly expanding access to our established tissue culture services and germplasm library outside of California with the right partners. Beyond cleaning up genetics, we also provide disease free tissue culture starts ready for market.
Want to know more? Send an email to tissueculture@phinest-tissueculture.com to discuss your tissue culture and nursery needs.
Top Genetics
Get access to our licensed germplasm bank comprised of hundreds of unique cultivars selected with our partners (or breeders).
Quality Control
Our constant pathogen indexing, and quality control measures allow us to produce mother stock that’s higher yielding and production-ready faster, improving the overall efficiency of nursery operations.
Proven Results
We have a proven track record remediating HLVd. Cultivars that we clean, stay clean.
